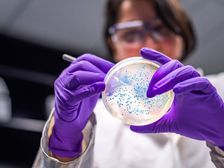
पोस्ट ग्रेजुएट डिप्लोमा इन माइक्रोबायोलॉजी (Career in PG Diploma in Microbiology)

Feature Articles in Hindi
Notifications
Settings
Clear Notifications Notifications
Use the toggle to switch on notifications
- Block for 8 hours
- Block for 12 hours
- Block for 24 hours
- Don't block
Log in for Better Reading Experience!
By signing in, you agree to our Terms and Privacy Policy
Gender
Select your Gender
- Male
- Female
- Others
Age
Select your Age Range
- Under 18
- 18 to 25
- 26 to 35
- 36 to 45
- 45 to 55
- 55+



 Click it and Unblock the Notifications
Click it and Unblock the Notifications